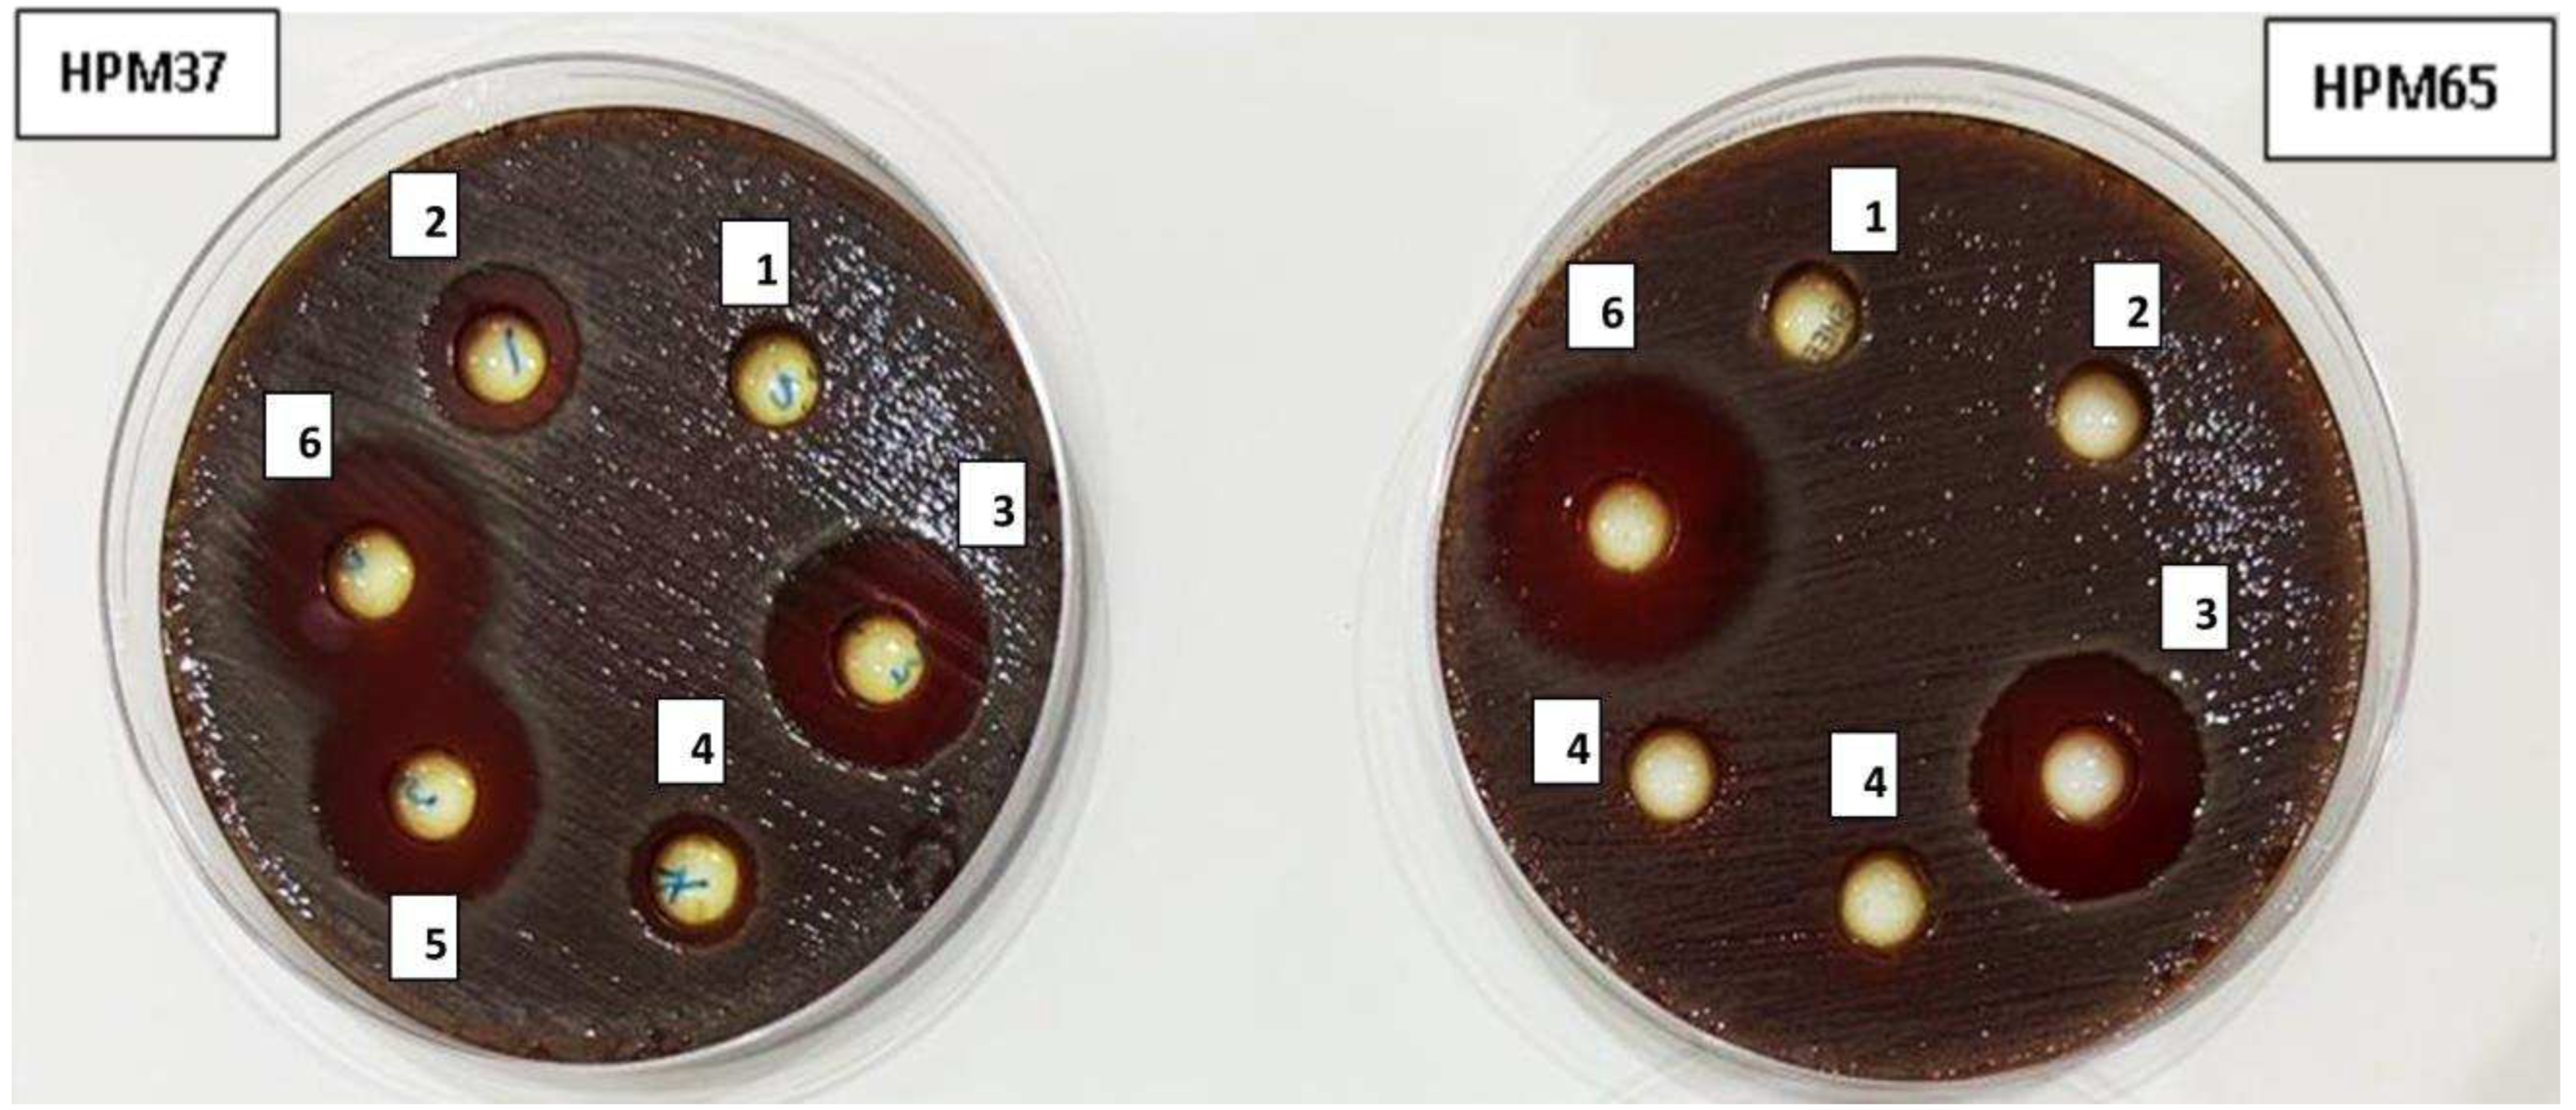

Submitted:
28 June 2023
Posted:
29 June 2023
You are already at the latest version
Abstract
Keywords:
1. Introduction
2. Materials and Methods
2.1. Zingiber officinale
2.1.1. Extract of Z. officinale (ZO) preparation
2.2. Antibiotic susceptibility of H. pylori isolates
2.3.1. Anti H. pylori activity of (ZO) extract
2.3.2. Determination of minimum inhibitory concentrations (MICs) of (ZO) extract
2.3. Checkerboard assay
2.4. Antibiofilm activity of methanolic extract Z. officinale
2.5. Anti-inflammatory assay by human RBCs
2.6. Identification of chemicals that constitute Z. officinale extract by GC-MS
2.7. Statistical analysis
3. Results
3.1. Antibiotics profile of H. pylori isolates
3.2. Antibacterial activity and minimum inhibitory concentration of Z. officinale extract
3.3. Synergistic effect of gentamicin combination with Z. officinale extract against resistant H. pylori isolate HPM72
3.3. Antibiofilm activity of Z. officinale extract

3.4. Anti-inflammatory activity of Z. officinale extract
3.5. Chemical Composition of Z. officinale extract
5. Conclusions
Author Contributions
Funding
Institutional Review Board Statement
Informed Consent Statement
Data Availability Statement
Conflicts of Interest
References
- El-Sherbiny GM, Mahmoud KM. A review – plant essential oils active against Helicobacter pylori. J. Essent. Oil Res. 34:3, 203-215, 2022. [CrossRef]
- Dunn BE, Cohen H, Blaser MJ. “Helicobacter pylori,” Clinical Microbiology Reviews, 10(4) 720–741, 1997.
- Blaser MJ, “Helicobacter pylori: its role in disease,” Clinical Infectious Diseases, vol. 15, no. 3, pp. 386–393, 1992. [CrossRef]
- Graham DY, “Campylobacter pylori and peptic ulcer disease,” Gastroenterology, vol. 96, no. 2, supplement 2, pp. 615–625, 1989. [CrossRef]
- Parsonnet J., Friedman G.D, Vandersteen DP, et al., “Helicobacter pylori infection and the risk of gastric carcinoma,” The New England Journal of Medicine, vol. 325, no. 16, pp. 1127–1131, 1991. [CrossRef]
- Wotherspoon C, Doglioni C, Diss TC. et al., “Regression of primary low-grade-B-cell gastric lymphoma of mucosa associated lymphoid tissue type after eradication of Helicobacter pylori,” The Lancet, vol. 342, no. 8871, pp. 575–577, 1993. [CrossRef]
- International Agency for Research on Cancer (IARC) 1994 and World Health Organization, “Schistosomes, liver flukes, and Helicobacter pylori,” in Monographs on the Evaluation of Carcinogenic Risks.
- Bonifácio B.V., Ramos A.S., Silva P.B., Taís M.B., Antimicrobial activity of natural products against Helicobacter pylori: a review. Annals of Clinical Microbiology and Antimicrobials, 13, 54 (2014). [CrossRef]
- Stark R. M., Gerwig G. J., Pitman R. S. et al., “Biofilm formation by Helicobacter pylori,” Letters in Applied Microbiology, vol. 28, no. 2, pp. 121–126, 1999. [CrossRef]
- Cole S. P., Harwood J., Lee R., She R., Guiney D. G., “Characterization of monospecies biofilm formation by Helicobacter pylori,” Journal of Bacteriology, vol. 186, no. 10, pp. 3124–3132, 2004. [CrossRef]
- Cellini L., Grande R., Campli E. et al., “Characterization of a Helicobacter pylori environmental strain,” Journal of Applied Microbiology, vol. 105, no. 3, pp. 761–769, 2008. [CrossRef]
- Hou. C., Yin F., Wang S., Zhao A., Li Y., Liu Y., Helicobacter pylori Biofilm-Related Drug Resistance and New Developments in Its Anti-Biofilm Agents Infection and Drug Resistance 2022:15 1561–1571. [CrossRef]
- Hathroubi S, Zerebinski J, Clarke A, Ottemann KM. Helicobacter pylori biofilm confers antibiotic tolerance in part via a protein-dependent mechanism. Antibiotics. 2020;9(6). [CrossRef]
- Okshevsky M, Meyer RL. The role of extracellular DNA in the establishment, maintenance and perpetuation of bacterial biofilms. Crit Rev Microbiol. 2015;41(3):341–352. [CrossRef]
- Ma JF, Hager PW, Howell ML, Phibbs PV, Hassett DJ. Cloning and characterization of the Pseudomonas aeruginosa zwf gene encoding glucose-6-phosphate dehydrogenase, an enzyme important in resistance to methyl viologen (paraquat). J Bacteriol. 1998;180(7):1741–1749. [CrossRef]
- Hsu, D.C. Wu, W.C. Chen, H.H. Tseng, H.C. Yu, H. M. Wang, S.S. Kao, K.H. Lai, A. Chen and F.W. Tsay, Randomized controlled trial comparing 7-day triple, 10-day sequential, and 7-day concomitant therapies for Helicobacter pylori infection. Antimicrobial Agents and Chemotherapy, 58(10), 5936–5942 (2014). [CrossRef]
- Bonifácio B.V., Dos Santos Ramos M.A., Da Silva P.B., et al., Antimicrobial activity of natural products against Helicobacter pylori: a review. Annals of Clinical Microbiology and Antimicrobials, 13(54), (2014). [CrossRef]
- Sharaf MH, El-Sherbiny GM, Moghannem SA, et al. New combination approaches to combat methicillin-resistant Staphylococcus aureus (MRSA). Sci Rep. 2021a;11(1):1–16. [CrossRef]
- Vale F.F. and Oleastro M., Overview of the phytomedicine approach against Helicobacter pylori. World Journal of Gastroenterology, 20(19), 5594–5609 (2014). [CrossRef]
- Wang Y.C., Medicinal plant activity on Helicobacter pylori-related diseases. World Journal of Gastroenterology, 20(30), 10368–10382 (2014). [CrossRef]
- Mahady G.B., PendlandS.L, YunG.S., Lu Z., Stoia A.Ginger (Zingiber officinale Roscoe) and the Gingerols Inhibit the Growth of Cag A+ Strains of Helicobacter pylori Anticancer Res. 2003 ; 23(0): 3699–3702.
- Ohno T., Kita M., Yamaoka Y., Imamura S., Yamamoto T., Mitsufuji S., Kodoma K., Kashima T., Imanishi, J. Antimicrobial activity of essential oils against Helicobacter pylori. Helicobacter, 8(3), 207–215 (2003). [CrossRef]
- Song MY, Lee DY, Park SY, Seo AA, Hwang JS., Heo SH, Kim EH Steamed Ginger Extract Exerts Anti-inflammatory Effects in Helicobacter pylori-infected Gastric Epithelial Cells through Inhibition of NF-κB. J Cancer Prev. 2021 30;26(4):289-297. [CrossRef]
- Clinical and Laboratory Standards Institute (CLSI) 2020 guidelines (M7-A5).
- Parekh, J., Chanda, S., 2007. Antibacterial and phytochemical studies on twelve species of Indian medicinal plants. Afr. J. Biomed. Res. 10: 175–181. [CrossRef]
- Foda A.M., Kalaba M.H., El-Sherbiny G.M., Moghannem S.A., El-Fakharany E.M. Antibacterial activity of essential oils for combating colistin-resistant bacteria Expert Rev. Anti-Infect. Ther., 20 (2022), pp. 1351-1364. [CrossRef]
- Kodori M., Nikmanesh B., Hakimi H., Ghalavand Z, Antibiotic Susceptibility and Biofilm Formation of Bacterial Isolates Derived from Pediatric Patients with Cystic Fibrosis from Tehran, Iran Archives of Razi Institute, Vol. 76, No. 2 (2021) 397-406. [CrossRef]
- Rahman H, Eswaraiah MC, Dutta A (2015) In-vitro anti-inflammatory and anti-arthritic activity of Oryza sativa Var. joha rice (an aromatic indigenous rice of Assam). Am Eurasian J Agric Environ Sci 15(1):115–121.
- El-Sherbiny GM, Gazelly AM, Sharaf MH. Moghannemm SA, Shehata M. .Ismail MKA, .El-Hawary AS, Exploitation of the antibacterial, antibiofilm and antioxidant activities of Salvadora persica (Miswak) extract Journal of Bioresources and Bioproducts 2022. [CrossRef]
- Thung I., Aramin H., Vavinskaya V., Gupta S., Park J. Y., Crowe S.E., Valasek M.A., Review article: the global emergence of Helicobacter pylori antibiotic resistance. Alimentary Pharmacology & Therapeutics, 43(4), 514–533 (2016).
- Rasheed F, Campbel BJ, Alfizah, H, Varro A, Zahra R, Yamaoka Y, Mark D, Pritchard Analysis of Clinical Isolates of Helicobacter pylori in Pakistan Reveals High Degrees of Pathogenicity and High Frequencies of Antibiotic Resistance. Helicobacter (2014) 19: 387–399. [CrossRef]
- Tan B., Yang JC, Young, C.L. et al. Helicobacter pylori Antimicrobial Susceptibility Testing-Guided Salvage Therapy in the USA: A Real Life Experience. Dig Dis Sci 63, 437–445 (2018). [CrossRef]
- Tshibangu-Kabamba, E., Yamaoka, Y. Helicobacter pylori infection and antibiotic resistance — from biology to clinical implications. Nat Rev Gastroenterol Hepatol 18, 613–629 (2021). [CrossRef]
- Gaynor M., Mankin, A. S. Macrolide antibiotics: binding site, mechanism of action, resistance. Curr. Top. Med. Chem. 3, 949–960 (2003). [CrossRef]
- Correia, S., Poeta, P., Hébraud, M., Capelo, J. L. & Igrejas, G. Mechanisms of quinolone action and resistance: where do we stand? J. Med. Microbiol. 66, 551–559 (2017). [CrossRef]
- Mori H., Suzuki H., Matsuzaki J., Masaoka T., Kanai T. Acquisition of double mutation in gyrA caused high resistance to sitafloxacin in Helicobacter pylori after unsuccessful eradication with sitafloxacin-containing regimens. United European Gastroenterol. J. 6, 391–397 (2018). [CrossRef]
- EL-Sherbiny GM. Antimicrobial Susceptibility of Bacteria Detected from the Root Canal Infection (Before and After) Root-Filled Teeth: An in Vitro Study International Journal of Dental Sciences and Research, 2015, Vol. 3, No. 1, 4-9.
- Chakotiya A S., Tanwar A., Narula A., Sharma RK, Zingiber officinale: Its antibacterial activity on Pseudomonas aeruginosa and mode of action evaluated by flow cytometry Microbial Pathogenesis 107, 2017, 254-260. [CrossRef]
- Jing Y, Cheng W, Ma Y, Zhang Y, Li M, Zheng Y, Zhang D and Wu L (2022) Structural Characterization, Antioxidant and Antibacterial Activities of a Novel Polysaccharide From Zingiber officinale and Its Application in Synthesis of Silver Nanoparticles. Front. Nutr. 9:917094. [CrossRef]
- Bhattamisra SK., Yean VL., Lee CK, Kuean CH, Candasamy M, Liew YK, Sahu PS Protective activity of geraniol against acetic acid and Helicobacter pylori- induced gastric ulcers in rats. Journal of Traditional and Complementary Medicine 9 (2019) 206e214. [CrossRef]
- Song MY, Lee DY, Park SY, Seo SA, Jeong-Seung Hwang JS, Heo AH, Kim EH, Steamed Ginger Extract Exerts Anti-inflammatory Effects in Helicobacter pylori-infected Gastric Epithelial Cells through Inhibition of NF-B. J Cancer Prev 26(4):289-297, 2021. [CrossRef]
- Azadi M, Ebrahimi A, Khaledi A, Esmaeili D, Study of inhibitory effects of the mixture of cinnamon and ginger extracts on cagA gene expression of Helicobacter pylori by Real-Time RT-PCR technique Gene Reports 17 (2019) 100493. [CrossRef]
- Fatemi, N., Sharifmoghadam, M.R., Bahreini, M. et al. Antibacterial and Synergistic Effects of Herbal Extracts in Combination with Amikacin and Imipenem Against Multidrug-Resistant Isolates of Acinetobacter. Curr Microbiol 77, 1959–1967 (2020). [CrossRef]
- Khameneh B, Iranshahy M, Ghandadi M, Ghoochi Atashbeyk D, Fazly Bazzaz BS, Iranshahi M (2015) Investigation of the antibacterial activity and efflux pump inhibitory effect of co-loaded piperine and gentamicin nanoliposomes in methicillin-resistant Staphylococcus aureus. Drug Dev Ind Pharm 41:989–994. [CrossRef]
- Lakshmi B.V. S; Sudhakar M. Protective Effect of Zingiber officinale on Gentamicin-Induced Nephrotoxicity in Rats International Journal of Pharmacology 2010; 6(1), 58-62.
- Sharma, S.; Mohler, J.; Mahajan, S.D.; Schwartz, S.A.; Bruggemann, L.; Aalinkeel, R. Microbial Biofilm: A Review on Formation, Infection, Antibiotic Resistance, Control Measures, and Innovative Treatment. Microorganisms 2023, 11, 1614. [CrossRef]
- Hoyle, B.D.; Wong, C.K.; Costerton, J.W. Disparate efficacy of tobramycin on Ca(2+)-, Mg(2+)-, and HEPES-treated Pseudomonas aeruginosa biofilms. Can. J. Microbiol. 1992, 38, 1214–1218. [. [CrossRef]
- Aghazadeh M, Bialvaei AZ, Aghazadeh M, Kabiri F, Saliani N, Mehdi Yousefi M, et al. Survey of the Antibiofilm and Antimicrobial Effects of Zingiber officinale (in Vitro Study) Jundishapur J Microbiol. 2016 February; 9(2): e30167.
- Faria TRB, Furletti-Goes VF, Franzini CM, et al Anti-inflammatory and antimicrobial effects of Zingiber officinale mouthwash on patients with fixed orthodontic appliances American Journal of Orthodontics and Dentofacial Orthopedics 159(1), 2021, 21-29. [CrossRef]
- Kim H-S, Park H-D (2013) Ginger Extract Inhibits Biofilm Formation by Pseudomonas aeruginosa PA14. PLoS ONE 8(9): e76106. [CrossRef]
- Mackay W., Gribbon L., Barer M. Reid D. Biofilms in drinking water systems: a possible reservoir for Helicobacter pylori. J. Appl. Microbiol. 85, 52S–59S (1998). [CrossRef]
- Sarem M., Corti, R. Role of Helicobacter pylori coccoid forms in infection and recrudescence. Gastroenterol. Hepatol. 39, 28–35 (2016). [CrossRef]
- Kadkhodaei, S., Siavoshi, F. & Akbari Noghabi, K. Mucoid and coccoid Helicobacter pylori with fast growth and antibiotic resistance. Helicobacter 25, e12678 (2020). [CrossRef]
- Ali BH, Blunden G, Tanira MO and Nemmar A: Some phytochemical, pharmacological and toxicological properties of ginger (Zingiber officinale roscoe): a review of recent research. Food and Chemical Toxicology 2008; 46(2): 409-20. [CrossRef]
- Charlier C., Michaux C, Dual inhibition of cyclooxygenase-2 (COX-2) and 5-lipoxygenase (5-LOX) as a new strategy to provide safer non-steroidal anti-inflammatory drugs. European Journal of Medicinal Chemistry 2003; 38(7): 645-59. [CrossRef]
- Grzanna R, Lindmark L and Frondoza CG: Ginger--an herbal medicinal product with broad anti-inflammatory actions. J Med Food 2005; 8(2): 125-32. [CrossRef]
- Elbashir DMM, Kehail MAA, Mohamed AIA, Ali AEH, Phytochemistry and GC-MS Screening and Biocidal Potentiality of Ginger (Zingiber officinale) Rhizome against Mosquito’s Larvae International Journal of Science and Research Archive, 2021, 03(02), 090–096. [CrossRef]
- Chinonye II, Oze RN, Lynda OU, Nkwoada A, Adanma AU. Phytochemical and GC/MS Analysis of the Rhizome of Zingiber officinale Plant Grown in Eastern Part of Nigeria. African Journal of Biology and Medical Research. 2018; 1(1): 43-54.
- Choudhari SS, Kareppa BM. Identification of Bioactive Compounds of Z. Officinale Roscoe Rhizomes through Gas Chromatography and Mass Spectrometry. Intern. J. Pharmac. Res. and Development. 2013; 5(8): 16 – 20.

| Class of antibiotics and mode of action | Antibiotic |
Potency (µg/disk) |
Antibiotics Susceptibility | Ref. normal value zone diameter breakpoints |
Ref. normal value H. pylori NCTC 11637 |
||||
| S. N (%) | I. N (%) | R. N (%) | S | I | R | ||||
| Inhibition of bacterial nucleic acid synthesis | |||||||||
| Fluoroquinolone | Ciprofloxacin | 5 | 45 (58.95) | 0(0.0) | 31 (40.61) | ≥ 21 | 16-20 | ≤ 15 | 22.40 |
| Quinolone | Levofloxacin | 5 | 39(51.09) | 9(11.79) | 28 (36.68) | ≥ 17 | 13–16 | ˂12 | 20.0 |
| Inhibition of bacterial protein synthesis | |||||||||
| Aminoglycosides | Gentamicin | 10 | 22 (28.82) | 16(20.96) | 38 (50.0) | ≥ 15 | 13-14 | ≤ 12 | 19.70 |
| Neomycin | 30 | 16(20.96) | 27(35.37) | 33 (43.23) | 21.0 | ||||
| Macrolides | Erythromycin | 15 | 30(39.30) | 12(15.72) | 34 (44.54) | ≥ 23 | 14-22 | ≤ 13 | 20.50 |
| Clarithromycin | 15 | 37 (48.47) | 9(11.79) | 30(39.30) | ≥21 | 15-20 | ≤14 | 21-70 | |
| Tetracyclines | Tetracycline | 30 | 19(24.89) | 22 (28.82) | 35 (45.85) | ≥ 19 | 15-18 | ≤ 14 | 23-80 |
| Inhibitors of bacterial cell wall synthesis | |||||||||
| Amoxicillin | 25 | 43 (56.33) | 8(10.48) | 25 (32.75) | ≥ 13 | 11-12 | ≤ 10 | 24.30 | |
| Penicillin combination | Amoxicillin-clavulanate | 20/10 | 56 (73.36) | 2(2.62.) | 18 (23.58) | ˃19 | - | ˂20 | 26.30 |
| Metabolic antagonism | |||||||||
| Nitroimidazoles | Metronidazole | 5 | 15(19.65) | 18 (23.58) | 43 (56.33) | ˃21 | 16-21 | ˂16 | 18.70 |
| No | Strains code | Mean of inhibition zone diameter (mm ± SD) | No | Strains code | Mean of inhibition zone diameter (mm ± SD) | ||
|---|---|---|---|---|---|---|---|
| Z. officinale extract | Gentamicin | Z. officinale extract | Gentamicin | ||||
| 1 | HPM4 | 14±00 | 0.0 | 14 | HPM48 | 12±05 | 0.0 |
| 2 | HPM7 | 13±09 | 0.0 | 15 | HPM51 | 15±20 | 0.0 |
| 3 | HPM9 | 12±05 | 0.0 | 16 | HPM54 | 24±04 | 0.0 |
| 4 | HPM12 | 11±05 | 0.0 | 17 | HPM57 | 14±06 | 0.0 |
| 5 | HPM15 | 15±09 | 0.0 | 18 | HPM62 | 12±04 | 0.0 |
| 6 | HPM16 | 13±03 | 0.0 | 19 | HPM63 | 13±06 | 0.0 |
| 7 | HPM19 | 15±00 | 0.0 | 20 | HPM65 | 16±00 | 0.0 |
| 8 | HPM26 | 12±04 | 0.0 | 21 | HPM66 | 11±04 | 0.0 |
| 9 | HPM37 | 16±00 | 0.0 | 22 | HPM70 | 10±03 | 0.0 |
| 10 | HPM44 | 11±06 | 0.0 | 23 | HPM72 | 12±07 | 0.0 |
| 11 | HPM48 | 15±08 | 0.0 | 24 | HPM73 | 14±08 | 0.0 |
| 12 | HPM52 | 12±00 | 0.0 | 25 | HPM75 | 15±08 | 0.0 |
| 13 | HPM56 | 14±06 | 0.0 | 26 | H. pylori NCTC 11637 | 17±06 | 20±04 |
| No | Strains code | Minimum inhibitory concentration (μg/ml) | No | Strains code | Minimum inhibitory concentration (μg/ml) |
|---|---|---|---|---|---|
| Z. officinale extract | Z. officinale extract | ||||
| 1 | HPM4 | 25.0 | 14 | HPM48 | 39.0 |
| 2 | HPM7 | 27.0 | 15 | HPM51 | 28.0 |
| 3 | HPM9 | 22.0 | 16 | HPM54 | 23.0 |
| 4 | HPM12 | 25.0 | 17 | HPM57 | 29.0 |
| 5 | HPM15 | 29.0 | 18 | HPM62 | 38.0 |
| 6 | HPM16 | 32.0 | 19 | HPM63 | 50.0 |
| 7 | HPM19 | 22.0 | 20 | HPM65 | 27.0 |
| 8 | HPM26 | 23.0 | 21 | HPM66 | 33.0 |
| 9 | HPM37 | 33.0 | 22 | HPM70 | 46.0 |
| 10 | HPM44 | 26.0 | 23 | HPM72 | 42.0 |
| 11 | HPM48 | 35.0 | 24 | HPM73 | 35.0 |
| 12 | HPM52 | 37.0 | 25 | HPM75 | 48.0 |
| 13 | HPM56 | 44.0 | 26 | H. pylori NCTC 11637 | 20.0 |
| No | MIC Gentamicin + MIC ZO extract |
Gentamicin + ZO extract (µg/ml) | FICI Gentamicin + FICI ZO extract | FICI | interpretation | MIC Gentamicin + MIC ZO extract |
|---|---|---|---|---|---|---|
| 1 | MIC+MIC | 42+33 | 1+1 | 2 | Indifference | MIC+MIC |
| 2 | MIC+1/2MIC | 42+16.5 | 1+0.5 | 1.5 | additive | MIC+1/2MIC |
| 3 | MIC+1/4MIC | 42+8,25 | 1+0.25 | 1.25 | additive | MIC+1/4MIC |
| 4 | MIC+1/8MIC | 42+4.13 | 1+0.125 | 1.125 | additive | MIC+1/8MIC |
| 5 | MIC+1/16MIC | 42+2.06 | 1+0.062 | 1.062 | additive | MIC+1/16MIC |
| 6 | MIC+1/32MIC | 42+1.03 | 1+0.031 | 1.031 | additive | MIC+1/32MIC |
| 7 | MIC+1/64MIC | 42+0,51 | 1+0.015 | 1.015 | additive | MIC+1/64MIC |
| 8 | MIC+1/128MIC | 42+0.25 | 1+0.007 | 1.007 | additive | MIC+1/128MIC |
| 9 | 1/2MIC+MIC | 21+33 | 0.5+1 | 1.5 | additive | 1/2MIC+MIC |
| 10 | 1/2MIC+1/2MIC | 21+16,5 | 0.5+0.5 | 1 | partial synergy | 1/2MIC+1/2MIC |
| 11 | 1/2MIC+1/4MIC | 21+8,25 | 0.5+0.25 | 0.75 | partial synergy | 1/2MIC+1/4MIC |
| 12 | 1/2MIC+1/8MIC | 21+4.13 | 0.5+0.125 | 0.625 | partial synergy | 1/2MIC+1/8MIC |
| 13 | 1/2MIC+1/16MIC | 21+2.06 | 0.5+0.062 | 0.562 | partial synergy | 1/2MIC+1/16MIC |
| 14 | 1/2MIC+1/32MIC | 21+1.03 | 0.5+0.031 | 0.531 | partial synergy | 1/2MIC+1/32MIC |
| 15 | 1/2MIC+1/64MIC | 21+0,51 | 0.5+0.015 | 0.515 | partial synergy | 1/2MIC+1/64MIC |
| 16 | 1/4MIC+MIC | 10.5+33 | 0.25+1 | 1.25 | additive | 1/4MIC+MIC |
| 17 | 1/4MIC+1/2MIC | 10.5+16.5 | 0.25+0.5 | 0.75 | partial synergy | 1/4MIC+1/2MIC |
| 18 | 1/4MIC+1/4MIC | 10.5+8.25 | 0.25+0.25 | 0.5 | synergy | 1/4MIC+1/4MIC |
| 19 | 1/4MIC+1/8MIC | 10.5+4.13 | 0.25+0.125 | 0.375 | synergy | 1/4MIC+1/8MIC |
| 20 | 1/4MIC+1/16MIC | 10.5+2.06 | 0.25+0.062 | 0.312 | synergy | 1/4MIC+1/16MIC |
| 21 | 1/4MIC+1/32MIC | 10.5+1.03 | 0.25+0.031 | 0.281 | synergy | 1/4MIC+1/32MIC |
| 22 | 1/8MIC+MIC | 5.25+33 | 0.125+1 | 1.125 | additive | 1/8MIC+MIC |
| 23 | 1/8MIC+1/2MIC | 5.25+16.5 | 0.125+0.5 | 0.625 | partial synergy | 1/8MIC+1/2MIC |
| 24 | 1/8MIC+1/4MIC | 5.25+8.25 | 0.125+0.25 | 0.375 | synergy | 1/8MIC+1/4MIC |
| 25 | 1/8MIC+1/8MIC | 5.25+4.14 | 0.125+0.125 | 0.25 | synergy | 1/8MIC+1/8MIC |
| 26 | 1/8MIC+1/16MIC | 5.25+2.06 | 0.125+0.062 | 0.187 | synergy | 1/8MIC+1/16MIC |
| 27 | 1/16MIC+MIC | 2.62+33 | 0.062+1 | 1.062 | additive | 1/16MIC+MIC |
| 28 | 1/16MIC+1/2MIC | 2.62+16.5 | 0.062+0.5 | 0.562 | partial synergy | 1/16MIC+1/2MIC |
| 29 | 1/16MIC+1/4MIC | 2.62+8.25 | 0.062+0.25 | 0.312 | synergy | 1/16MIC+1/4MIC |
| 30 | 1/32MIC+MIC | 1.31+33 | 0.031+1 | 1.031 | additive | 1/32MIC+MIC |
| 31 | 1/32MIC+1/2MIC | 1.31+16.5 | 0.031+0.5 | 0.531 | partial synergy | 1/32MIC+1/2MIC |
| 32 | 1/32MIC+1/4MIC | 1.31+8.25 | 0.031+0.25 | 0.281 | synergy | 1/32MIC+1/4MIC |
| 33 | 1/64MIC+MIC | 0.65+33 | 0.015+1 | 1.015 | additive | 1/64MIC+MIC |
| 34 | 1/64MIC+1/2MIC | 0.65+16.5 | 0.015+0.5 | 0.515 | partial synergy | 1/64MIC+1/2MIC |
| 35 | 1/64MIC+1/4MIC | 0.65+8.25 | 0.015+0.25 | 0.265 | synergy | 1/64MIC+1/4MIC |
| 36 | 1/128MIC+MIC | 0.22+33 | 0.007+1 | 1.007 | additive | 1/128MIC+MIC |
| 37 | 1/128MIC+1/2MIC | 0.32+16.5 | 0.007+0.5 | 0.507 | partial synergy | 1/128MIC+1/2MIC |
| 38 | 1/128MIC+1/4MIC | 0.32+8.25 | 0.007+0.25 | 0.257 | synergy | 1/128MIC+1/4MIC |
| Treatment | Number of bacterial isolates biofilm formation (%) | Degree (%) | |||
|---|---|---|---|---|---|
| Weak (%) | Moderate (%) | Strong (%) | |||
| Untreated | 0.0 µg/ml | 71(93.36) | 23.93 | 60.54 | 15.48 |
| Z. officinale | 25 µg/ml | 40(52.6) | 30.0 | 45.0 | 25.0 |
| 50 µg/ml | 5(6.31) | 0.0 | 40.0 | 60.0 | |
| Gentamicin | 25 µg/ml | 43(56.54) | 25.57 | 44.17 | 30.22 |
| 50 µg/ml | 2(2.63) | 0.0 | 100 | 0.0 | |
| Treatment | Concentration (μg/ml) | Absorbance 560 nm | Percentage inhibition |
|---|---|---|---|
| Control | 0.0 | 1.246 | 0.0 |
| Z. officinale | 4 | 0.625 | 49.83% |
| 8 | 0.536 | 56.68% | |
| 16 | 0.501 | 59.79% | |
| 32 | 0.480 | 61.47% | |
| Sodium diclofenac | 4 | 0.452 | 63.72% |
| 8 | 0.405 | 67.49% | |
| 16 | 0.384 | 69.18% | |
| 32 | 0.357 | 71.43% |
| Peak | Rotation Time | Contents % | Compound name | Molecular Formula | Molecular weight |
|---|---|---|---|---|---|
| 1 | 9.18 | 0.68 | Decanal | C10H20O | 156 |
| 2 | 16.85 | 0.98 | Dodecanamine, N, N-dimethyl- | C14H31N | 213 |
| 3 | 18.89 | 10.50 | Thymol | C10H14O | 150 |
| 4 | 20.55 | 3.26 | Phenol, 2-methyl-5-(1-methylethyl)- Carvacrol | C10H14O | 150 |
| 5 | 22.74 | 2.32 | Eugenol | C10H12O2 | 166 |
| 6 | 23.88 | 0.47 | Alpha-terpineol | C10H20O | 156 |
| 7 | 26.24 | 2.14 | Butanedioic acid, 2,3-bis(acetyloxy) | C8H14O8 | 182 |
| 8 | 27. 39 | 0.76 | Benzenediamine, 2,5-dimethoxy-alpha | C12H17NO2 | 207 |
| 8 | 30. 15 | 655 | Shogaol | C19H28O3 | 304 |
| 10 | 31.35 | 45.05 | Gingerol | C17H28O4 | 246 |
| 12 | 32.83 | 16.05 | Zingiberene | C15H27 | 207 |
| 13 | 34.72 | 3.44 | Beta-bisabolene | C15H22 | 200 |
| 14 | 36.15 | 2.26 | E-11-hexadecenoic acid, ethyl ester | C18H34O2 | 282 |
| 15 | 37.90 | 6.69 | Cyclohexane, 3-(1,5-dimethyl-4-hexenyl)- | C15H24 | 204 |
| 16 | 39.35. | 1.25 | Farnesyl acetone | C18H27O | 269 |
| 17 | 42.16 | 1.26 | Desoxo-9x-hydroxy-7-ketoingol 3,8,9,12-tetraacetate | C28H38O10 | 534 |
Disclaimer/Publisher’s Note: The statements, opinions and data contained in all publications are solely those of the individual author(s) and contributor(s) and not of MDPI and/or the editor(s). MDPI and/or the editor(s) disclaim responsibility for any injury to people or property resulting from any ideas, methods, instructions or products referred to in the content. |
© 2023 by the authors. Licensee MDPI, Basel, Switzerland. This article is an open access article distributed under the terms and conditions of the Creative Commons Attribution (CC BY) license (http://creativecommons.org/licenses/by/4.0/).
